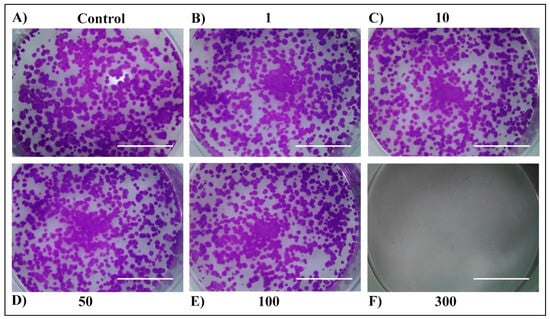
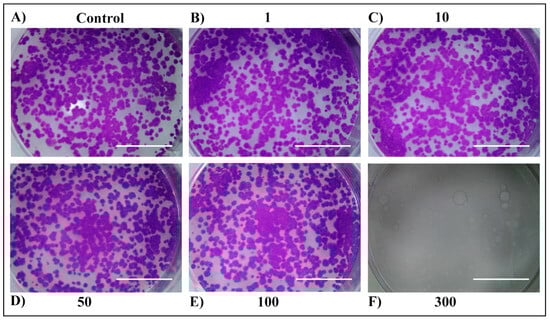
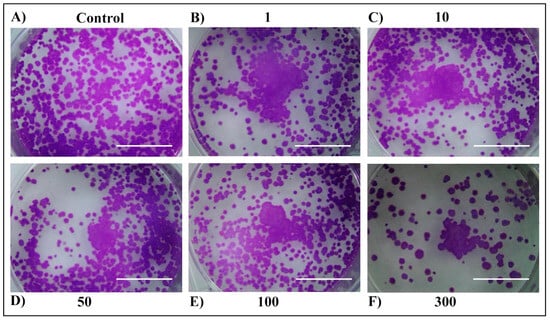
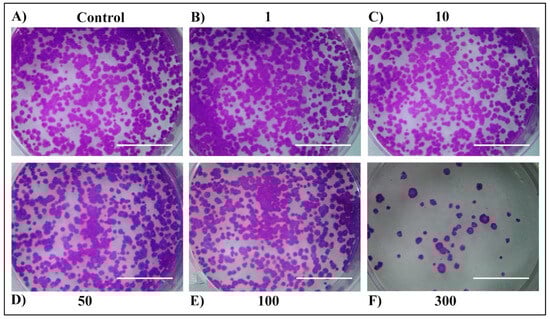

Abstract
Since ancient times, many plant species within the Thymus genus have been used due to their numerous health benefits, such as antimicrobial, anti-inflammatory, antiseptic, or diuretic activity. While many of the species within this genus were well known and described, Thymus pannonicus All. or Pannonian thyme remains relatively unexplored despite its unique chemical composition and activity. T. pannonicus is a small shrub, spread over central and eastern Europe, with a diverse, location-dependent chemical composition. Within this study, the citral chemotype of T. pannonicus was used, which up to our knowledge was found and described only in Northern Serbia. Therefore, in order to explore the composition of T. pannonicus low-polar extracts and to present a preliminary insight into their bioactivity, supercritical carbon dioxide (ScCO2) extraction was applied (with and without pre-treatments), followed by GC-MS analysis. Different ScCO2 extraction pressures were tested (100, 150, 200, 250, and 300 bar) in order to determine the most suitable conditions for the extraction of T. pannonicus’s low-polar fraction. Additionally, in order to maximize the yield of the extraction, two types of ScCO2 extraction pre-treatments were investigated (enzymatic and microwave). The highest extraction yield obtained from untreated plant material was 3.01% (w/w), and it was obtained at conditions of 150 bar and 40 °C, while the 4% (v/w) enzymatic pre-treatment, with the same conditions, provided a yield of 3.89%. For all of the obtained extracts, the GC-MS analysis showed that oxygenated monoterpenes and sesquiterpenes were the two most dominant groups with principal bioactive compounds such as (E)-citral (18.95–38.17%), (Z)-citral (6.68–14.66%), β-bisabolene (8.2–14.4%), and nerol (6.08–9.67%). The extracts that exhibited the highest concentration of principal bioactive compounds ((Z)-citral, and (E)-citral) were further analyzed for anticancer potential, using short- and long-term cell viability observations on liver cancer cells.
1. Introduction
Consisting of approximately 250 different species and varieties distributed over Europe, Asia, and Africa, the genus Thymus is one of the most important and taxonomically complex genera within the Lamiaceae family []. Within the Thymus genus, several species have been used, since ancient times, for the production of essential oils (EOs), mainly because of their numerous health-beneficial effects []. It has been proven that the most common and major EO components occurring within the Thymus genus are phenol monoterpene derivatives of cymene, thymol, and carvacrol. Specifically, species like T. vulgaris (common thyme) and T. zygis (Spanish thyme) are of high commercial importance due to their high contents of thymol []. Thanks to the number of bioactive constituents, plant species within this genus are considered important medicinal plants. Therefore, many studies investigated their different medicinal effects such as antimicrobial, anti-inflammatory, antiseptic, antirheumatic, carminative, diuretic, and expectorant potentials.
Thymus pannonicus All. (Hungarian or Pannonian thyme) is a relatively unexplored species; it is a small shrub, 10–25 cm high, spread over central and eastern Europe. In the scientific literature, a couple of different chemotypes have been recorded, such as the Ukrainian chemotype (33.7–70.2% geraniol and 65.8% carvacrol), the Bosnian chemotype (13.7% thymol), or the German chemotype, which contains high levels of geranyl acetate []. For this study, a characteristic T. pannonicus citral chemotype was used. The T. pannonicus citral chemotype is only found and described in Northern Serbia, and contrary to all other described chemotypes, it contains geranial and neral (41.4 and 29.6%, respectively) as major components of its essential oil []. The essential oil of T. pannonicus has a characteristic lemon-like scent due to the high contents of geranial and neral, which when combined create citral. Thanks to the pleasant aroma, the dried herb of T. pannonicus has traditionally been used for the preparation of herbal tea drinks or the aromatization of food. Also, it has been used as a remedy for coughs and respiratory problems, as well as for the treatment of gastrointestinal disorders. Although there are just a couple of studies that investigated the medicinal activity of this citral chemotype of T. pannonicus, the available results stated that the essential oil of this plant exhibited potent antibacterial activity []. Additionally, it was reported that deodorized water extracts of T. pannonicus, obtained as a residual product in the process of essential oil production, exhibited potential cytotoxic and antiproliferative activities [].
Within this study, supercritical carbon dioxide (ScCO2) extraction was applied for the isolation and preparation of a T. pannonicus low-polar fraction. On the contrary, the traditional extraction techniques like Soxhlet extraction, which requires high temperatures, usage of toxic organic solvents, and prolonged extraction time, the ScCO2 extraction has none of the aforementioned negative characteristics. This means that isolated low-polar fractions, due to the low process temperatures, preserve their high-quality chemical composition (higher quality as thermal degradation is avoided), and there is no trace of unused solvent (including organic ones), which enables direct use of the produced isolate. The ScCO2 extraction uses inert gas, carbon dioxide, in its supercritical state, which means that the process of extraction is conducted at a temperature higher than 31.1 °C and a pressure higher than 73.8 bar. While in a supercritical state, CO2 obtains the characteristics of both a gas and liquid, with high liquid-like density and high diffusivity similar to gases. These characteristics, in addition to CO2 nontoxicity, make it an excellent solvent for low-polar and lipophilic compound extraction from various plant matrices. Additionally, it was proved that the pressure of extraction influences the CO2 density and, therefore, directly impacts the extraction’s yield and selectivity [].
In order to improve the efficiency of the conventional supercritical extraction procedure, and at the same time to stay in line with the green chemistry concept, different green pre-treatments of the plant material were conducted to potentially increase the efficiency and the yield of the isolated bioactive components. Many recent studies described the usage of different types of pre-treatments such as mechanical, enzymatic, or chemical which are designed to disrupt the cellular structure of the plant material and therefore increase the extraction yield. A study conducted by Meyer et al. in 2012 [] showed that flaking rapeseed in a roller mill increased the extraction yield 3.5 times, in comparison to the other pre-treatment techniques, while Crampon et al. 2013 [] demonstrated the influence of different drying pre-treatments. In accordance with our previous research (Vladić et al. 2021 []), within this study, enzymatic and microwave pre-treatments were applied to raw T. pannonicus plant material to increase both the yield of the extraction as well as the recovery of the principal bioactive compounds.
In addition, according to the available literature, a significant number of papers reflect on the promising cytotoxic effects of many Thymus species on cancer cell lines []. However, currently, no studies are focusing on non-polar T. pannonicus extracts and their beneficial effect as a potential anticancer agent. Therefore, within this study, preliminary assessment of the potential anticancer activity of T. pannonicus low-polar extracts on rat hepatoma cell lines was performed. Hence, this is the first report on such investigations to broaden the medical significance of this species and represents a preliminary basis for advanced analysis of the molecular mechanisms involved in their effects.
Considering all that was mentioned above, the present study focused on two main process aspects in order to obtain the high-quality T. pannonicus fractions/low-polar extracts applying the green approach: (a) analysis of the impact of the process pressure (as a dominant process parameter) on the composition of the isolated low lipid fraction and (b) the coupling of the ScCO2 extraction process with the microwave and enzymatic pre-treatments to achieve improved isolation of the targeted and most valuable constituents. In order to assess the quality of the obtained extracts, a comprehensive GC-MS analysis was performed, and the contents of the identified non-polar compounds were compared. Additionally, for the extracts that exhibited the highest concentrations of the principal bioactive compounds ((Z)-citral and (E)-citral) for both untreated and pre-treated plant material, potential anticancer activity was assessed in terms of the short-term and long-term cytotoxic activity on rat hepatoma cells lines (H4IIE).
2. Results and Discussion
2.1. ScCO2 Extraction Yield
The ScCO2 extraction of T. pannonicus has been conducted with five different extraction pressures (100, 150, 200, 250, and 300 bar) and a fixed temperature (40 °C) and CO2 flow rate (0.27 kg/h). In addition, two different extraction pre-treatments, enzymatic (ENZ1 and ENZ2) and microwave (MW), were applied (Table 1).

Table 1.
Conditions of ScCO2 extractions for each T. pannonicus plant material sample.
Results with the low-pressure ScCO2 extraction (100 bar) provided a significantly lower yield of 1.14% (w/w) in comparison to all other runs conducted at higher pressures. This low yield obtained on the 100-bar extraction may be the consequence of the physical characteristics of CO2 at 100 bar and 40 °C, where its density (0.629 g/cm3) is not yet suitable for the extraction of most of T. pannonicus low-polar compounds. Immediately after the lowest pressure value, the second run—the ScCO2 extraction at 150 bar—provided the highest yield of 3.01% (w/w). After this point, an increase in the ScCO2 extraction pressure resulted in a slight but gradual drop in the extraction yield. These results indicate that the characteristics of the supercritical CO2 in terms of density and viscosity were the most suitable at 150 bar (Table 2, Figure 1). Additionally, a gradual drop in extraction yields also indicated that the primary low-polar components in T. pannonicus were of monoterpene and sesquiterpene structures rather than fatty acids and waxes, which was also confirmed by GC-MS analysis.

Table 2.
Yield of ScCO2 extraction. Significant difference between samples (p < 0.05) is indicated by different letters.

Figure 1.
Yield of ScCO2 extraction for each extraction condition. Significant difference between samples (p < 0.05) is indicated by different letters.
Similar results, in the extraction of some other herbs or oil-containing materials, were recorded by several studies. In Machmudah et al. 2007 [], where the ScCO2 extraction of rosehip seeds was conducted with pressures ranging from 150 bar to 490 bar and a constant temperature of 40 °C, the highest yield was obtained at 150 bar, and a gradual drop in yields was seen with the increase up to 250 bar. In accordance, Morsy 2020 [] reported that ScCO2 extraction of Thymus vulgaris with an extraction pressure of 16.7 MPa and temperature of 40 °C was the best method to obtain thymol-rich extracts. Additionally, Xiong K. and Chen Y. 2020 [] reported that out of three tested extraction pressures (100, 150, and 200 bar), the ScCO2 extraction of tangerine peel essential oils provided the best results at 150 bar, and the kinetic model showed that optimal extraction conditions were 45 °C, 140 bar, and 147 min of extraction.
Because the extraction yield was highest at 150 bar, pre-treated T. pannonicus plant material was extracted at that pressure, and the effects of the pre-treatment were investigated. Keeping in mind the primary nature of low-polar compounds in the raw plant material, some losses during the pre-treatments were expected, and in accordance, the introduction of pre-treatments had a different influence on the extraction yield.
By applying the enzymatic pre-treatment, the disruption of the plant material integrity and enhanced extraction occurs due to enzyme hydrolysis of the plant cell wall structures []. Primarily, the plant cell walls consist of a complex network of cellulose, hemicellulose, pectin, and proteins which are essential for maintaining proper functioning of the cell. Different enzyme groups such as cellulase, carbohydrase, hemicellulase, and protease hydrolyze the components of the cell walls leading to increased cell wall permeability or disruption of the cell wall in its totality, which then facilitates the extraction of biocomponents []. The application of enzyme pre-treatments to extractions results in reduced extraction time, less solvent and energy consumption, and an increase in the extraction yield without degradation of targeted biomolecules; however, this procedure is demanding in terms of process parameters such as very specific temperature and pH requirements []. Considering a number of the studies reporting its effectiveness in cell wall disruption, a cellulolytic enzyme mixture Viscozyme (carbohydrase, arabanase, cellulase, β-glucanase, hemicellulase, and xylanase) was also used within this study for the pre-treatment of T. pannonicus plant material.
Application of 4% (v/w) cell-wall degrading enzyme (ENZ1) provided a yield of 3.89% which is a significant increase in the extraction yield of 14.65% (1.17 times) compared to untreated plant material. Vladić et al. 2021 [] reported a similar increase in the ScCO2 extraction yield when oregano plant material was pre-treated with the same cell-wall degrading enzyme mixture at a concentration of 8%. The lower concentration of enzyme (2%) has not influenced the increase in the T. pannonicus extraction yield, and the result was just slightly lower than the extraction of untreated material at 150 bar. This slight drop in the extraction yield can be attributed to the losses during the process of pre-treating the material.
Contrary to the enzymatic pre-treatment, with the application of the microwave pre-treatment (MW), the plant material receives microwave irradiation directly through interactions with the electromagnetic field and the polar molecules such as water (moisture) within the matrix. As a result, heat is rapidly generated throughout the whole volume of the material, offering reduced processing time and less energy consumption. In addition, rapid delivery of the energy causes internal superheating of the material which subsequently disrupts both internal and external cell structures of the plant material which facilitates extraction procedures and recovery of the biomolecules [,].
Microwave pre-treatment showed a significantly lower yield in the extraction compared to both ENZ1 pre-treatment and extraction of untreated material. This drop in extraction yield is most likely the consequence of the chemical structure and polarity of the identified compounds, which were most likely extracted during the pre-treatment itself. Additionally, this also indicates that the power of MW pre-treatment was too strong which led to rapid degradation of the plant material’s cell walls and the extraction of targeted compounds. Regardless, although the yield of the extraction was decreased by the application of the MW pre-treatment, later GC-MS analysis showed that the MW extract exhibited high concentrations of principal bioactive compounds (highest content of (Z)-citral). Comparably, Da Porto et al. 2016 [] reported that the application of MW pre-treatment increases the yield of an ScCO2 extraction of M. oleifera seeds up to a point of 1.5 min pre-treatment time and a power of 100 W. In conclusion, the results of this study indicate that acquiring the highest T. pannonicus ScCO2 extraction yield is achieved with a 4% enzymatic pre-treatment in combination with a pressure of 150 bar, while the MW pre-treatment provided an extract rich in bioactive compounds.
2.2. Gas Chromatography–Mass Spectrometry (GC-MS) Analysis
The yield of ScCO2 extraction is by itself an important parameter and indicator of the successful extraction process because it provides first-hand information about the quality and characteristics of the investigated plant material. However, in order to have complete insight into the bioactivity of the obtained extract, a detailed analysis needs to be conducted with the purpose of determining principal bioactive components. Therefore, the GC-MS analysis was conducted for T. pannonicus fractions obtained for all extraction conditions. Additionally, the application of pre-treatments induced an increase in the extraction yield, but it is also important to determine whether the treatment impacted the bioactive components; therefore, the GC-MS analysis was conducted for all of the extracts obtained using pre-treated samples. The GC-MS analysis results showed a total of 38 detected components in the investigated samples, representing from 90.l6 to 96.2% of the extract, depending on the extraction conditions. Out of the identified compounds, two dominant groups emerged: oxygenated monoterpenes and sesquiterpenoids. Oxygenated monoterpenes accounted for 46.98% of the extract obtained at a pressure of 100 bar (E1) and up to 72.9% of the extract obtained at 150 bar (E2). In total, only the extract obtained at 100 bar had less than 50% oxygenated monoterpene. The second most dominant group of components, sesquiterpenoids, made up from 19.08 to 28.94% of the obtained extracts (Table 3; Figure 2).

Table 3.
The GC/MS analysis of T. pannonicus extracts obtained by ScCO2 with different extraction conditions (E1–E5) and different applied pre-treatments (ENZ1, ENZ2, and MW). The obtained results were presented as % of total identified compounds, calculated as a relative peak area, and the principal components were highlighted.

Figure 2.
Percentage of the oxygenated monoterpene and sesquiterpenoids for all of the obtained T. pannonicus low-polar extracts [%].
Similar results were reported in the study by Maksimović et al. 2008 [], which analyzed the essential oil of the same citral chemotype of T. pannonicus, where GC-MS analysis showed that 97.75% of the essential oil was composed of oxygenated monoterpenes. Maksimović et al. 2008 [] also identified the presence of monoterpene hydrocarbons, sesquiterpenes, and oxygenated sesquiterpenes in much lower concentrations and characterized them as background components which is also in accordance with the results reported within this study. Contrary to this study, Maksimović et al. 2008 [] reported that 71% of the oxygenated monoterpenes within the essential oil were geranial (41.42%) and neral (29.61%), which in combination create the lemon-scented citral. Within this study, however, it is proved that the extracts do not have geranial and neral in their composition but, rather, have their isomeric forms; that is, the extracts possess high concentrations of (Z)-citral (6.68–14.66%) and (E)-citral (18.95–38.17%). The reason for this difference was probably due to the different applied extraction techniques because the ScCO2 extraction was conducted at a mild temperature of 40 °C, while hydrodistillation required a temperature of about 100 °C, which could lead to the temperature transformation of certain compounds, as well degradation of the most heat-sensitive ones.
The GC-MS analysis of T. pannonicus ScCO2 extracts showed the presence of several distinct principal bioactive compounds (Figure 3). Noticeably, bioactive components that were in the highest content, with the variations depending on the extraction conditions, were the following: (E)-citral (18.95–38.17%), (Z)-citral (6.68–14.66%), β-bisabolene (8.2–14.4%), nerol (6.08–9.67%), and neryl acetate (2.15–4.57%), as well as neric acid, germacrene D, spathulenol, and α-cadinol, which were in slightly reduced concentrations. Up to now, there are several published studies which reported on the bioactivity of these compounds. Chaouki et al. 2009 [] reported that citral treatment had a high antiproliferative effect on the MCF-7 breast cancer cell line. Additionally, Sheikh et al. 2017 [] reported that citral treatment induced apoptosis in human colorectal HCT116 and HT29 cell lines. A recent study by Nabila et al. 2024 [] reported that sesquiterpene β-bisabolene has potential antidiabetic activity, while nerol and neryl acetate exhibit antibacterial activity against several bacterial strains [].

Figure 3.
Total ion chromatogram (TIC) for the sample E1, with the x-axis representing time [min] and the y-axis representing signal intensity.
The results of the GC-MS analysis also showed that several distinct differences could be observed between extracts obtained from the untreated plant material at pressures from 150 bar to 300 bar and the extract obtained from the same material at 100 bar of pressure. Compared to other extracts, E1 had the lowest content of oxygenated monoterpenes (46.98%) and the highest content of sesquiterpenoids (29.94%). Additionally, E1 showed a distinctively high content of compounds that were present in low concentration in all other extracts, specifically bisabolol oxide A (5.88%), 1,2-benzendicarboxylic acid (4.8%), spathulenol (7.01%), and α-cadinol (5.62%). A common characteristic for all of these compounds is that their molecular weights are distributed in close proximity (188.11, 220.35, 222.37, and 238.37 g/mol for 1,2-benzendicarboxylic acid, spathulenol, α-cadinol, and bisabolol oxide, respectively), which can be the reason why the density of CO2 at 100 bar was the most suitable for their extraction. Additionally, the location of these compounds in specific parts of the plant material (surface layers) can also influence their better extraction with a lower ScCO2 extraction pressure.
The ScCO2 extraction conditions resulted in the highest content of oxygenated monoterpenes (72.9%) in the E2 extract, the one obtained at a pressure of 150 bar. Accordingly, the highest concentrations of (Z)-citral and (E)-citral in the extracts obtained without pre-treatment were recorded in the same E2 extract (14.66 and 38.17%, respectively). For the other bioactive compounds, the highest values were distributed among the extracts obtained with ScCO2 pressure conditions from 200 to 300 bar. Extract E3 had the highest concentration of neryl acetate (4.76%) and extract E5 had the highest concentration of nerol and neric acid (9.70 and 7.76%, respectively). The concentration of sesquiterpenes obtained with ScCO2 pressure conditions from 150 to 300 bar (E2–E5) was in the range from 19.08 to 26.35%, with the extract E3 having the highest content of germacrene D and β-bisabolene (3.78 and 13.37%, respectively).
Pre-treatments of T. pannonicus plant material led to high concentrations of total oxygenated monoterpenes in all the obtained extracts. Interestingly, pre-treatments that resulted in lower extraction yields (ENZ2 and MW) had a higher concentration of oxygenated monoterpenes compared to ENZ1 which increased the yield of ScCO2 extraction. Additionally, while the ENZ1 extract had a higher concentration of (E)-Citral (35.62%), both ENZ2 and MW had higher concentrations of (Z)-citral (11.99 and 14.82, respectively). Application of enzymatic pre-treatments resulted in extracts with the highest recorded concentration of the sesquiterpenoid compound β-bisabolene of 14.4% (ENZ1), while microwave pre-treatment resulted in the highest concentrations of (Z)-citral and germacrene D (14.82 and 4.10%, respectively). In addition, it is important to mention that the application of enzymatic pre-treatments resulted in the presence of acetic acid in the obtained extracts since the pre-treatment itself was conducted in an acetate buffer. This distribution in concentrations of bioactive compounds is a clear indication that with the change in ScCO2 extraction conditions the properties of the CO2 as a solvent change, and, therefore, the selectivity of the extraction changes. Additionally, these results also indicate that the application of plant material pre-treatments, in addition to the increase in the yield of the extraction, can alter the composition of low-polar compounds in ScCO2 extracts with the same extraction conditions.
2.3. Anticancer Potential
The cytotoxic and anticancer potential of EOs, extracts, and phytocompounds of different Thymus species have been explored, particularly using in vitro cellular models []. Thymus spp. has shown anticancer potential in lung adenocarcinoma, prostate cancer cells, breast cancer cells, ovarian cancer cells, and leukemia [,,,]. However, so far, no information regarding the antiproliferative effect of ScCO2 low-polar extracts of T. pannonicus was found in the literature.
In this study, rat hepatoma cells (H4IIE) were used to examine the effects of 0–300 μg/mL of a supercritical CO2 extract of T. pannonicus, with or without microwave pre-treatment, on short- and long-term cell viability. For this analysis, extracts E2 and MW were selected based primarily on the concentration of (Z)-citral and (E)-citral, as two of the principal bioactive components with reported anticancer activity. Both the E2 and MW extracts exhibited the highest concentration of (Z)-citral for raw and pre-treated plant material (14.66 and 14.82%, respectively). For the concentration of (E)-citral, E2 exhibited the highest concentration of 38.17%; MW had the second highest concentration of 35.59%. Although, in order to have a complete assessment, all of the extracts should be analyzed. This study serves as a preliminary investigation into the anticancer potential of the T. pannonicus low-polar extracts, as well as citral as a bioactive compound. Therefore, within this study, only extracts E2 and MW were analyzed for short-term and long-term cell viability, while the subsequent studies will aim to produce comprehensive research into the anticancer potential of T. pannonicus low-polar fractions.
As a first approach method, the MTT assay was used to estimate the potential cytotoxicity of the extracts on the cancer cell line after 24 h and 48 h of treatment (Figure 4). After 24 h and 48 h of treatment, neither the E2 nor MW extract showed cytotoxic effects compared to control. On the contrary, a slight increase in cell viability was observed after incubation with low doses of the extracts. This increment in cell viability is not surprising and could be attributed to their antioxidant potential [].

Figure 4.
Effects of different concentrations of T. Pannonicus E2 (A,B) and MW (C,D) extracts, in the concentration range 0–300 µg/mL, on H4IIE short-term cell viability after 24 h and 48 h of treatment. Data are presented as mean ± S.D. * p < 0.05; # p < 0.001.
For long-term cell survival observation, a colony-formation assay was performed (Figure 5, Figure 6, Figure 7 and Figure 8). First, no difference was observed between 24 h and 48 h of treatment within the same extract. Second, both extracts exerted a strong anticancer potential, but only when used at the concentration of 300 µg/mL. The third, stronger anticancer potential was observed in the E2 extract, in which none of the colonies could be found when treated with 300 µg/mL, compared to the MW extract, in which a small number of colonies remained. The higher anticancer potency of the E2 extract in comparison to the MW extract could be attributed to the better extraction yield and total terpene profile. This discrepancy between the short-term and long-term cell cytotoxicity could be due to the delayed effects of the extracts, which are mechanism dependent. The cytotoxic effect could arise by triggering different cell death pathways. Many genes are effective in apoptosis which is the most important cell death pathway []. Even though the mechanism of the observed anticancer potential of tested extracts in H4IIE cells is unknown, due to their low-polar nature, monoterpenes and sesquiterpenoids appear to increase the permeability of the cell membrane, leading to the generation of metabolites and enzyme leakage [,].
Figure 5.
Long-term survival of H4IIE cells following the 24 h treatment with T. Pannonicus E2 extract in the concentration range 0–300 µg/mL. (A) Control. (B) Extract concentration 1 μg/mL. (C) Extract concentration 10 μg/mL. (D) Extract concentration 50 μg/mL. (E) Extract concentration 100 μg/mL. (F) Extract concentration 300 μg/mL. The scale bar represents 1 cm.
Figure 6.
Long-term survival of H4IIE cells following the 48 h treatment with T. Pannonicus E2 extract in the concentration range 0–300 µg/mL. (A) Control. (B) Extract concentration 1 μg/mL. (C) Extract concentration 10 μg/mL. (D) Extract concentration 50 μg/mL. (E) Extract concentration 100 μg/mL. (F) Extract concentration 300 μg/mL. The scale bar represents 1 cm.
Figure 7.
Long-term survival of H4IIE cells following the 24 h treatment with T. Pannonicus MW extract in the concentration range 0–300 µg/mL. (A) Control. (B) Extract concentration 1 μg/mL. (C) Extract concentration 10 μg/mL. (D) Extract concentration 50 μg/mL. (E) Extract concentration 100 μg/mL. (F) Extract concentration 300 μg/mL. The scale bar represents 1 cm.
Figure 8.
Long-term survival of H4IIE cells following the 48 h treatment with T. Pannonicus MW extract in the concentration range 0–300 µg/mL. (A) Control. (B) Extract concentration 1 μg/mL. (C) Extract concentration 10 μg/mL. (D) Extract concentration 50 μg/mL. (E) Extract concentration 100 μg/mL. (F) Extract concentration 300 μg/mL. The scale bar represents 1 cm.
Furthermore, citral is the principal component in both extracts. Duerksen-Hughes et al. 1999 [] established the genotoxic property of citral due to the p53 protein increase, resulting in DNA damage. Moreover, Souza et al. 2020 [] indicated the significant genotoxic impact of citral in the human hepatocellular HepG2 cell line. Generally, the biological activity of plant extracts is related to their phytochemical composition. Nevertheless, the less present phytochemicals must be considered, since the extract’s compounds could show synergistic/additive effects [,]. Whether citral alone or in combination with other components of the ScCO2 extracts is responsible for the observed cytotoxicity against liver cancer cells remains to be established.
3. Materials and Methods
3.1. Plant Material and Chemicals
T. pannonicus whole plant material was provided from the personal cultivation of Prof. Dr Zoran Maksimović, Institute of Pharmacognosy, School of Pharmacy, University of Belgrade. The plant material was air dried, the content of moisture was 7.87%, and it was determined using a standard gravimetric procedure. After the drying, the herb was ground using an industrial scale mill to a mean particle size of 0.49 mm which was calculated using vibration sieve sets (CISA, Cedaceria, Spain).
Carbon dioxide for the ScCO2 extraction with a purity > 99.98% (w/w) was obtained from a local provider Messer, Novi Sad, Serbia. Viscozyme, a cellulolytic enzyme complex (carbohydrases, arabanase, cellulase, β-glucanase, hemicellulose, and xylanase) that was used for the enzymatic pre-treatment, was purchased from Sigma-Aldrich (St. Louis and Burlington, MA, USA).
3.2. Enzymatic Pre-Treatment of Plant Material
Enzymatic pre-treatment of T. pannonicus plant material was conducted with two different concentrations of the cellulolytic enzyme Viscozyme. The first enzymatic pre-treatment was conducted with 4% Viscozyme (v/w), while the concentration for the second pre-treatment was 2% (v/w). The percentage was calculated based on the dry weight of the plant material, and the samples were marked as ENZ1 and ENZ2 for the 4 and 2% Viscozyme concentration, respectively. In both samples, Viscozyme was dissolved in an acetate buffer solution (pH 4.6) and mixed with the T. pannonicus plant material. The ratio of plant material to buffer solution was 1:5 (w/v), and after mixing, the mixture was tempered at 45 °C for 60 min. After the tempering, the plant material was separated from the buffer solution using vacuum filtration and freeze-dried for 48 h. The dried material was used for the ScCO2 extraction.
3.3. Microwave Pre-Treatment of Plant Material
The second type of pre-treatment was the disruption of plant material cell structures using microwave irradiation. Firstly, plant material was mixed, in a round flask, with distilled water in a ratio of 1:5 (w/v) and placed in a modified commercial microwave oven (NN-E201W, Panasonic, Osaka, Japan). The microwave irradiation power was set to 800 W, and the time of pre-treatment was 2 min. The appropriate time and power for the pre-treatment were determined based on previous research []. After the pre-treatment, plant material was separated from the liquid phase using vacuum filtration and freeze-dried for 48 h (Alpha 1–2 LPlus, Christ, Osterode am Harz, Germany). The dried samples were used for the ScCO2 extraction.
3.4. Supercritical Carbon Dioxide Extraction
For the supercritical carbon dioxide (ScCO2) extraction, a laboratory-scale, high-pressure system (HPEP, NOVA-Swiss, Effretikon, Switzerland) was used. The main components of the ScCO2 extraction system were a CO2 gas container, high-pressure compressor (pressure range up to 1000 bar), extraction unit (200 mL volume; maximum working pressure of 700 bar), separation unit (200 mL volume; maximum working pressure of 250 bar), pressure control valves system, temperature control unit, and regulation valves.
The extraction for the untreated plant material was performed at five different pressures (100, 150, 200, 250, and 300 bar) at the constant extraction temperature of 40 °C and with an extraction time of 3 h. Because the yield of the extraction was highest for the conditions of 150 bar and 40 °C, the enzymatic- and microwave-pre-treated plant material was processed by supercritical CO2 only under those conditions. For all of the extractions, pressure in the separation unit was held at 150 bar, and the flow of ScCO2 was constant at 0.27 kg/h. For each extraction run, 30 g of ground and dried plant material was used, and each extraction was performed in triplicate. Obtained extracts were collected in plastic cuvettes, protected from direct sunlight, and stored at 4 °C for further analysis.
3.5. Gas Chromatography–Mass Spectrometry (GC-MS) Analysis
GC-MS analysis was performed using an Agilent Technologies (Palo Alto, CA, USA) gas chromatograph model 7890A coupled with a 5975C mass detector (Agilent Technologies). For the analysis, an HP-5MS capillary column was used (5% phenyl-methylpolysiloxane stationary phase, 30 m length, 0.25 mm diameter, and coating thickness of 0.25 μm). The carrier gas was helium at 1 mL/min, while the temperature of the injector was 250 °C. The oven temperature was programmed to be isothermal at 70 °C for 2 min, increasing from 70 to 200 °C at 3 °C/min, and held isothermally at 200 °C for 15 min. The split ratio was 1:20, and the ionisation voltage was 70 eV; the ion source temperature was 230 °C, and the temperature of the quadrupole was 150 °C. The scanning mass range was from 30 to 450 amu. The percentage of the components was calculated from the GC peak areas as mean values from duplicate GC-MS analysis of all the extracts.
For the solid phase microextraction of the T. pannonicus ScCO2 extracts, a DVB/CAR/PDMS fiber was chosen (grey fiber with an 80 μm film thickness, Supelco Co., Bellefonte, PA, USA). Before use, the fiber was activated at 250 °C, in accordance with the manufacturer’s instructions. After the conditioning procedure, the fibers were used to extract a 0.01 g T. pannonicus extract sample which was placed in the 20 mL glass vial and hermetically sealed with a stopper with a septum. The PAL system automatically sampled the peak vapors of the T. pannonicus extract for 40 min with periodic mixing. After collecting the surface vapors, the fibers were transferred to a GC-MS injector (250 °C) for thermal desorption for 7 min. The analysis started immediately after the injection of the fiber into the inlet of the device.
The identification of the compounds was conducted using Wiley9 (New York, NY, USA), Nist11 (Gaithersburg, MD, USA), and the Pest database within the ChemStation (OpenLab CDS 2.7) software by Agilent (Palo Alto, CA, USA). For all of the components, the Kovats index was calculated and compared with the specters from said databases.
3.6. Cell Culture
Rat hepatoma cells were obtained from the American Type Culture Collection (H4IIE cell line, ATCC® CRL-1548TM, Manassas, VA, USA). The cells were cultivated as a monolayer culture in polystyrene flasks with MEM medium, supplemented with 10% (v/v) fetal bovine serum, 100 U/mL penicillin, 0.1 mg/mL streptomycin, and 2 mM glutamine. Further, the cells were grown in a 5% CO2 atmosphere at 37 °C in humidified conditions. After reaching the exponential phase of growth, the cells were subsequently subcultured twice a week at a 1:10 ratio using 0.05% trypsine/EDTA. All reagents were from Capricorn Scientific GmbH, Ebsdorfergrund, Germany.
3.7. Preparation of Extract Solutions for Cellular Assays
The ScCO2 extracts of T. pannonicus plant material obtained at 150 bar and 40 °C with (MW) or without microwave pre-treatment (E2) were further tested for cytotoxicity. These extracts were dissolved in dimethylsulfoxide (DMSO) and diluted in the MEM medium before the treatment. To avoid false cytotoxic effects, the percentage of DMSO did not exceed 0.1%. The cells were treated for 24 h and 48 h with concentrations ranging from 0 to 300 µg/mL of the tested extracts (marked as 1, 10, 50, 100, and 300). Control was treated with 0.1% DMSO.
3.8. MTT Assay
The short-term cell viability was determined using the MTT (3-(4,5-Dimethylthiazol-2-yl)-2,5-diphenyl tetrazolium bromide) assay as we described earlier []. Twenty-four hours after seeding 20,000 cells per well in 96-well plates, the culture medium was replaced by a fresh medium containing the prepared extract solutions with the desired concentration. Following the treatment for 24 h and 48 h, the viability of the H4IIE cells was determined by the ability of viable cells to produce formazan from MTT []. Briefly, the medium-containing extracts were discarded, 0.5 mg/mL of MTT (Sigma-Aldrich, USA) dissolved in MEM medium was added to each well, and the plates were incubated at 37 °C for 3 h. Cell lysis and dissolution of formazan crystals were accomplished by adding 0.04 M HCl/isopropanol. The absorbance was read on a microplate spectrophotometer (Multiscan MCC340, Labsystems, Huntsville, AL, USA) at 540/690 nm. Cell viability was calculated as the percentage of viable cells in comparison to untreated cells (control). The assay was repeated three times in quadruplicate.
3.9. Colony-Forming Assay
A colony-forming assay was performed to determine the long-term cytotoxicity of tested extracts, where the effects of 24 h and 48 h treatments on small cell numbers were followed for two weeks. Twenty-four hours after seeding 2000 cells per well in 6-well plates, the culture medium was replaced by a fresh medium containing the prepared extract solutions with the desired concentration. Following the treatment for 24 h and 48 h, the tested extracts solutions were discarded, and for the next 14 days, the cells were maintained in a fresh complete medium. Following the cell fixation with methanol, cells were dyed with 0.5% crystal violet solution (Sigma-Aldrich). Representative images for each group were taken using a stereomicroscope (OZR 564, KERN Optics, Balingen, Germany).
3.10. Statistical Analysis
Results from the MTT assay were analyzed using IBM SPSS version 26 (Chicago, IL, USA). Data are expressed as mean ± standard deviation (S.D.). The Shapiro–Wilk test was used to assess the normality of the data. To determine the existence of significant differences between the groups, data were analyzed with the one-way analysis of variance (ANOVA), followed by the Tukey test. A p-value lower than 0.05 was considered significant.
4. Conclusions
The results obtained within this study provided clearer insight into the characteristics of the T. pannonicus citral chemotype, in terms of the content of low-polar molecules, the presence of principal bioactive molecules, and its cytotoxic and anticancer potential. Additionally, green and ecologically safe ScCO2 extraction was applied at five different extraction pressures, with two different extraction pre-treatments (enzymatic and microwave), in order to determine the best approach for the utilization of this valuable plant material. The yield of ScCO2 extraction varied depending on the extraction pressure and the pre-treatment applied, with the highest achieved yield of untreated plant material obtained for the extract E2 (150 bar; 40 °C) which was 3.01% (w/w). Application of the enzymatic pre-treatment ENZ1 (4% Viscozyme, 150 bar, and 40 °C) led to an increase in the extraction yield and provided the total highest yield of 3.89% (w/w), which was an increase compared to E2 of 14.65%. GC-MS analysis was conducted for all of the extracts, and several principal bioactive components were detected, such as (E)-citral (18.95–38.17%), (Z)-citral (6.68–14.66%), nerol (6.08–9.67%), and β-bisabolene (8.2–14.4%). Additionally, GC-MS analysis showed that the extracts were mainly composed of oxygenated monoterpenes and sesquiterpenoides, with the highest content of oxygenated monoterpenes (72.9%) recorded in the extract E2. For the determination of the cytotoxic and anticancer potential, E2 and MW extracts were selected based on their concentrations of (Z)-citral and (E)-citral, and their anticancer potential was assessed for the short- and long-term cell viability of rat hepatoma cells (H4IIE). While the MTT assay that was used for estimation of the short-term cell viability did not show activity for the tested extracts, a colony-formation assay for long-term cell survival observation showed that extracts at the concentration of 300 μg/mL exhibit strong anticancer activity against H4IIE rat hepatoma cells.
Supplementary Materials
The following supporting information can be downloaded at: https://www.mdpi.com/article/10.3390/plants13243457/s1.
Author Contributions
Conceptualization, A.G., S.S., and S.V.; methodology, A.G., J.D.L., S.S., and S.V.; software, J.D.L. and K.A.; validation, A.G., N.M., and S.V.; formal analysis, K.A., J.D.L., and S.S.; investigation, S.S. and J.D.L.; resources, S.J., S.V., and Z.M.; data curation, K.A. and S.S.; writing—original draft preparation, J.D.L. and S.S.; writing—review and editing, A.G., N.M., and S.V.; visualization, S.S.; supervision, S.V. All authors have read and agreed to the published version of the manuscript.
Funding
This research was funded by the Ministry of Science, Technological Development and Innovation of the Republic of Serbia, Project No. 451-03-66/2024-03/200134. Additional funding was provided through two Grant Agreements between the Ministry of Science, Technological Development, and Innovation of the Republic of Serbia and the University of Belgrade, Faculty of Pharmacy: Grant No. 451-03-65/2024-03/200161 and Grant No. 451-03-66/2024-03/200161.
Data Availability Statement
The original contributions presented in this study are included in the article/Supplementary Materials. Further inquiries can be directed to the corresponding authors.
Conflicts of Interest
The authors declare no conflicts of interest.
References
- Casiglia, S.; Bruno, M.; Scandolera, E.; Senatore, F.; Senatore, F. Influence of harvesting time on composition of the essential oil of Thymus capitatus (L.) Hoffmanns. & Link. growing wild in northern Sicily and its activity on microorganisms affecting historical art crafts. Arab. J. Chem. 2019, 12, 2704–2712. [Google Scholar]
- Salehi, B.; Mishra, A.P.; Shukla, I.; Sharifi-Rad, M.; Contreras, M.D.M.; Segura-Carretero, A.; Sharifi-Rad, J. Thymol, thyme, and other plant sources: Health and potential uses. Phytother. Res. 2018, 32, 1688–1706. [Google Scholar] [CrossRef] [PubMed]
- Basch, E.; Ulbricht, C.; Hammerness, P.; Bevins, A.; Sollars, D. Thyme (Thymus vulgaris L.), thymol. J. Herb. Pharmacother. 2004, 4, 49–67. [Google Scholar] [CrossRef] [PubMed]
- Pluhár, Z.; Sárosi, S.; Pintér, A.; Simkó, H. Essential oil polymorphism of wild growing Hungarian thyme (Thymus pannonicus) populations in the Carpathian Basin. Nat. Prod. Commun. 2010, 5, 1934578X1000501034. [Google Scholar] [CrossRef]
- Maksimović, Z.; Milenković, M.; Vučićević, D.; Ristić, M. Chemical composition and antimicrobial activity of Thymus pannonicus All.(Lamiaceae) essential oil. Open Life Sci. 2008, 3, 149–154. [Google Scholar] [CrossRef]
- Ćebović, T.; Arsenijević, J.; Drobac, M.; Živković, J.; Šoštarić, I.; Maksimović, Z. Potential use of deodorised water extracts: Polyphenol-rich extract of Thymus pannonicus All. as a chemopreventive agent. J. Food Sci. Technol. 2018, 55, 560–567. [Google Scholar] [CrossRef]
- Arumugham, T.; Rambabu, K.; Hasan, S.W.; Show, P.L.; Rinklebe, J.; Banat, F. Supercritical carbon dioxide extraction of plant phytochemicals for biological and environmental applications—A review. Chemosphere 2021, 271, 129525. [Google Scholar] [CrossRef]
- Meyer, F.; Jaeger, P.; Eggers, R.; Stamenic, M.; Milovanovic, S.; Zizovic, I. Effect of CO2 pre-treatment on scCO2 extraction of natural material. Chem. Eng. Process. Process Intensif. 2012, 56, 37–45. [Google Scholar] [CrossRef]
- Crampon, C.; Mouahid, A.; Toudji, S.A.A.; Lépine, O.; Badens, E. Influence of pretreatment on supercritical CO2 extraction from Nannochloropsis oculata. J. Supercrit. Fluids 2013, 79, 337–344. [Google Scholar] [CrossRef]
- Vladić, J.; Duarte, A.R.C.; Radman, S.; Simić, S.; Jerković, I. Enzymatic and microwave pretreatments and supercritical CO2 extraction for improving extraction efficiency and quality of Origanum vulgare L. spp. hirtum extracts. Plants 2021, 11, 54. [Google Scholar] [CrossRef]
- Afonso, A.F.; Pereira, O.R.; Cardoso, S.M. Health-promoting effects of Thymus phenolic-rich extracts: Antioxidant, anti-inflammatory and antitumoral properties. Antioxidants 2020, 9, 814. [Google Scholar] [CrossRef] [PubMed]
- Machmudah, S.; Kondo, M.; Sasaki, M.; Goto, M.; Munemasa, J.; Yamagata, M. Pressure effect in supercritical CO2 extraction of plant seeds. J. Supercrit. Fluids 2008, 44, 301–307. [Google Scholar] [CrossRef]
- Morsy, N.F. Production of thymol rich extracts from ajwain (Carum copticum L.) and thyme (Thymus vulgaris L.) using supercritical CO2. Ind. Crops Prod. 2020, 145, 112072. [Google Scholar] [CrossRef]
- Xiong, K.; Chen, Y. Supercritical carbon dioxide extraction of essential oil from tangerine peel: Experimental optimization and kinetics modelling. Chem. Eng. Res. Des. 2020, 164, 412–423. [Google Scholar] [CrossRef]
- Puri, M.; Sharma, D.; Barrow, C.J. Enzyme-assisted extraction of bioactives from plants. Trends Biotechnol. 2012, 30, 37–44. [Google Scholar] [CrossRef]
- Krakowska-Sieprawska, A.; Kiełbasa, A.; Rafińska, K.; Ligor, M.; Buszewski, B. Modern methods of pre-treatment of plant material for the extraction of bioactive compounds. Molecules 2022, 27, 730. [Google Scholar] [CrossRef]
- Meyer, A.S. Enzyme technology for precision functional food ingredient processes. Ann. N. Y. Acad. Sci. 2010, 1190, 126–132. [Google Scholar] [CrossRef]
- Wang, L.; Weller, C.L. Recent advances in extraction of nutraceuticals from plants. Trends Food Sci. Technol. 2006, 17, 300–312. [Google Scholar] [CrossRef]
- Uquiche, E.; Jeréz, M.; Ortíz, J. Effect of pretreatment with microwaves on mechanical extraction yield and quality of vegetable oil from Chilean hazelnuts (Gevuina avellana Mol). Innov. Food Sci. Emerg. Technol. 2008, 9, 495–500. [Google Scholar] [CrossRef]
- Da Porto, C.; Decorti, D.; Natolino, A. Microwave pretreatment of Moringa oleifera seed: Effect on oil obtained by pilot-scale supercritical carbon dioxide extraction and Soxhlet apparatus. J. Supercrit. Fluids 2016, 107, 38–43. [Google Scholar] [CrossRef]
- Chaouki, W.; Leger, D.Y.; Liagre, B.; Beneytout, J.L.; Hmamouchi, M. Citral inhibits cell proliferation and induces apoptosis and cell cycle arrest in MCF-7 cells. Fundam. Clin. Pharmacol. 2009, 23, 549–556. [Google Scholar] [CrossRef]
- Sheikh, B.Y.; Sarker MM, R.; Kamarudin MN, A.; Mohan, G. Antiproliferative and apoptosis inducing effects of citral via p53 and ROS-induced mitochondrial-mediated apoptosis in human colorectal HCT116 and HT29 cell lines. Biomed. Pharmacother. 2017, 96, 834–846. [Google Scholar] [CrossRef]
- Nabila, B.Z.; Surya, M.I.; Lailaty, I.Q.; Damayanti, F.; Nuringtyas, T.R. Antidiabetic Potential and Metabolite Profile of Leaf and Stem Extract of Castanopsis tungurrut (Blume) A. DC. J. Pharm. Sci. 2024, 1, 107. [Google Scholar]
- Kotan, R.; Kordali, S.; Cakir, A. Screening of antibacterial activities of twenty-one oxygenated monoterpenes. Z. Für Naturforschung C 2007, 62, 507–513. [Google Scholar] [CrossRef]
- Jaafari, A.; Mouse, H.A.; Rakib, E.M.; M’barek, L.A.; Tilaoui, M.; Benbakhta, C.; Zyad, A. Chemical composition and antitumor activity of different wild varieties of Moroccan thyme. Rev. Bras. Farmacogn. 2007, 17, 477–491. [Google Scholar] [CrossRef]
- Zu, Y.; Yu, H.; Liang, L.; Fu, Y.; Efferth, T.; Liu, X.; Wu, N. Activities of ten essential oils towards Propionibacterium acnes and PC-3, A-549 and MCF-7 cancer cells. Molecules 2010, 15, 3200–3210. [Google Scholar] [CrossRef]
- Ramadan, M.M.; Ali, M.M.; Ghanem, K.Z.; El-Ghorabe, A.H. Essential oils from Egyptian aromatic plants as antioxidant and novel anticancer agents in human cancer cell lines. Grasas Y Aceites 2015, 66, e080. [Google Scholar]
- Salehi, B.; Abu-Darwish, M.S.; Tarawneh, A.H.; Cabral, C.; Gadetskaya, A.V.; Salgueiro, L.; Hosseinabadi, T.; Rajabi, S.; Chanda, W.; Sharifi-Rad, M.; et al. Thymus spp. plants-Food applications and phytopharmacy properties. Trends Food Sci. Technol. 2019, 85, 287–306. [Google Scholar] [CrossRef]
- Briz, O.; Serrano, M.A.; Macias, R.I.; Marin, J.J. Overcoming cisplatin resistance in vitro by a free and liposome-encapsulated bile acid derivative: BAMET-R2. Int. J. Cancer 2000, 88, 287–292. [Google Scholar] [CrossRef]
- Celen Yuceturk, S.; Aydogan Turkoglu, S.; Kockar, F.; Kucukbay, F.Z.; Azaz, A.D. Essential oil chemical composition, antimicrobial, anticancer, and antioxidant effects of Thymus convolutus Klokov in Turkey. Z. Für Naturforschung C 2021, 76, 193–203. [Google Scholar] [CrossRef]
- Bard, M.; Albrecht, M.R.; Gupta, N.; Guynn, C.J.; Stillwell, W. Geraniol interferes with membrane functions in strains of Candida and Saccharomyces. Lipids 1988, 23, 534–538. [Google Scholar] [CrossRef]
- Sikkema JA, N.; de Bont, J.A.; Poolman, B. Mechanisms of membrane toxicity of hydrocarbons. Microbiol. Rev. 1995, 59, 201–222. [Google Scholar] [CrossRef]
- Duerksen-Hughes, P.J.; Yang, J.; Ozcan, O. p53 induction as a genotoxic test for twenty-five chemicals undergoing in vivo carcinogenicity testing. Environ. Health Perspect. 1999, 107, 805–812. [Google Scholar] [CrossRef]
- Souza, A.C.; Silva, L.K.; Queiroz, T.B.; Marques, E.S.; Hiruma-Lima, C.A.; Gaivão, I.O.; Maistro, E.L. Citral presents cytotoxic and genotoxic effects in human cultured cells. Drug Chem. Toxicol. 2020, 43, 435–440. [Google Scholar] [CrossRef]
- Bakkali, F.; Averbeck, S.; Averbeck, D.; Zhiri, A.; Baudoux, D.; Idaomar, M. Antigenotoxic effects of three essential oils in diploid yeast (Saccharomyces cerevisiae) after treatments with UVC radiation, 8-MOP plus UVA and MMS. Mutat. Res./Genet. Toxicol. Environ. Mutagen. 2006, 606, 27–38. [Google Scholar] [CrossRef]
- Berdowska, I.; Zieliński, B.; Fecka, I.; Kulbacka, J.; Saczko, J.; Gamian, A. Cytotoxic impact of phenolics from Lamiaceae species on human breast cancer cells. Food Chem. 2013, 141, 1313–1321. [Google Scholar] [CrossRef]
- Drljača, J.; Popović, A.; Bulajić, D.; Stilinović, N.; Novaković, S.V.; Sekulić, S.; Milenković, I.; Ninković, S.; Ljubković, M.; Čapo, I. Diazepam diminishes temozolomide efficacy in the treatment of U87 glioblastoma cell line. CNS Neurosci. Ther. 2022, 28, 1447–1457. [Google Scholar] [CrossRef]
- Mosmann, T. Rapid colorimetric assay for cellular growth and survival: Application to proliferation and cytotoxicity assays. J. Immunol. Methods 1983, 65, 55–63. [Google Scholar] [CrossRef]
Disclaimer/Publisher’s Note: The statements, opinions and data contained in all publications are solely those of the individual author(s) and contributor(s) and not of MDPI and/or the editor(s). MDPI and/or the editor(s) disclaim responsibility for any injury to people or property resulting from any ideas, methods, instructions or products referred to in the content. |
© 2024 by the authors. Licensee MDPI, Basel, Switzerland. This article is an open access article distributed under the terms and conditions of the Creative Commons Attribution (CC BY) license (https://creativecommons.org/licenses/by/4.0/).